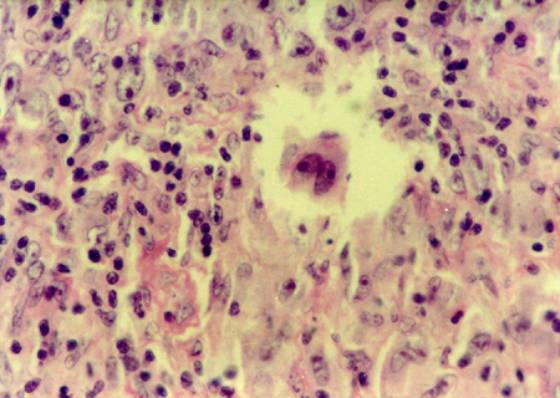

何杰金病(Hodgkin's disease)
何杰金病(Hodgkin's disease)是原发于淋巴结的恶性肿瘤,可能来源于巨噬细胞。
诊断要点:
1.常见于男性,20~40岁多见。
2.特异性皮损为结节或斑块,可溃破,偶为皮下结节。
3.非特异性皮损多见,常为表皮剥脱、红斑、广泛苔藓样变等,偶可发生红皮病、带状疱疹。35%有剧痒。
4.患者周围淋巴结无痛性肿大,常见于颈、腋或阴股部。
5.组织病理示瘤细胞成分复杂,伴各种炎症细胞和毛细血管增生,常形成肉芽肿。其瘤巨细胞称R-S细胞,有诊断价值。
治疗要点:
X线照射对限局型有效。III、IV期患者以化疗为主,宜同时采用多种药物联合化疗。